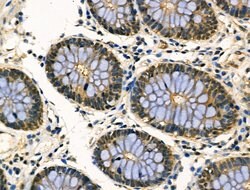
Invitrogen MYF5 Polyclonal Antibody 100 &mu;L; Unconjugated:Antibodies,

missing translation for 'onlineSavingsMsg'
Learn More
Learn More
Description
Antibody detects endogenous levels of total MYF5.
Myogenic factor 5 (MYF5) is a gene located on chromosome 12q21.31, encoding a basic helix-loop-helix (bHLH) transcription factor essential for skeletal muscle development and differentiation. MYF5 is one of the key members of the myogenic regulatory factor (MRF) family, which also includes MyoD, myogenin, and MRF4. It plays a crucial role in myogenesis by regulating the expression of genes necessary for muscle precursor cell proliferation and differentiation into mature muscle fibers. During embryonic development, MYF5 is involved in the formation of muscle tissue and maintenance of muscle progenitor cells. Mutations or dysregulation in MYF5 can lead to developmental abnormalities in muscle formation and are implicated in muscle-related disorders. Research into MYF5 continues to explore its regulatory mechanisms in muscle biology and potential therapeutic applications in muscular dystrophies and muscle repair processes.

Specifications
Specifications
| Antigen | MYF5 |
| Applications | Immunohistochemistry (Paraffin), Western Blot, Immunocytochemistry |
| Classification | Polyclonal |
| Concentration | 1 mg/mL |
| Conjugate | Unconjugated |
| Formulation | PBS with 50% glycerol and 0.02% sodium azide; pH 7.4 |
| Gene | MYF5 |
| Gene Accession No. | P13349, P24699 |
| Gene Alias | B130010J22Rik; basic helix-loop-helix nuclear protein; bHLHc2; cb641; Class C basic helix-loop-helix protein 2; muscle regulatory protein Myf5; MYF5; myf-5; myf5 protein; MyoD family; myogenic factor 5; myogenic factor-5; myogenic regulatory factor 5; myogenic regulatory factor MYF-5; unnamed protein product; zgc:110509 |
| Gene Symbols | MYF5 |
| Show More |
Product Title
By clicking Submit, you acknowledge that you may be contacted by Fisher Scientific in regards to the feedback you have provided in this form. We will not share your information for any other purposes. All contact information provided shall also be maintained in accordance with our Privacy Policy.
Spot an opportunity for improvement?